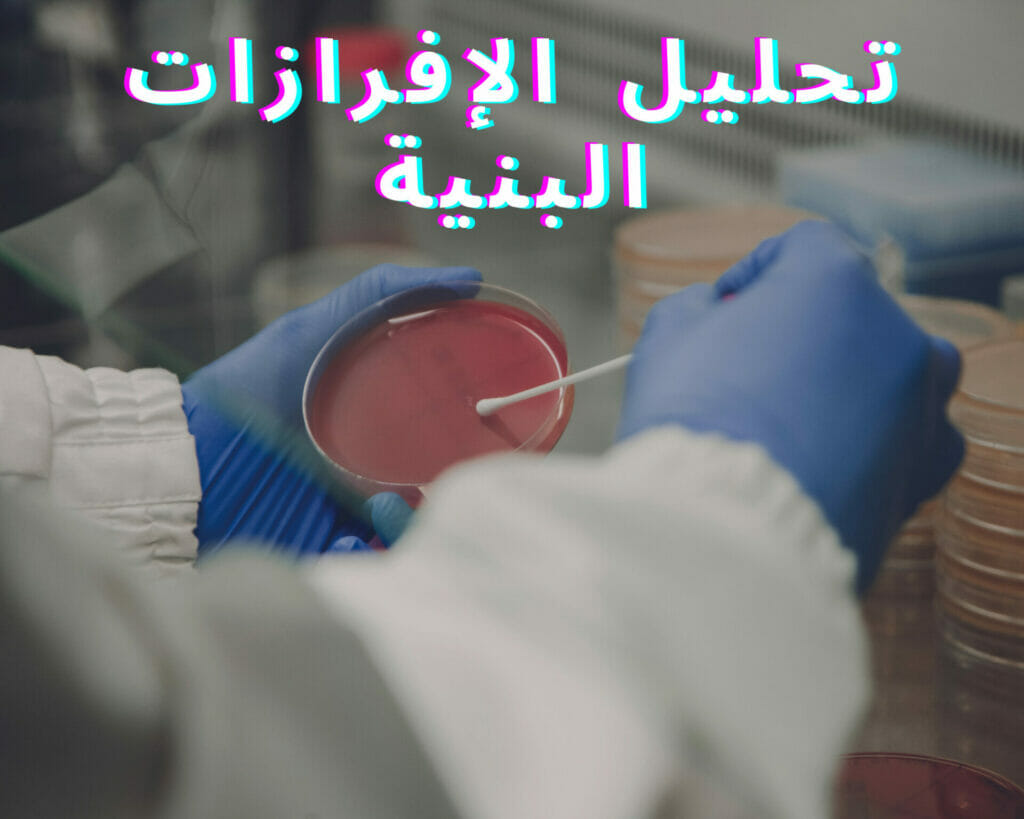
تحليل الإفرازات البنية

اسباب نزول افرازات بنية بالشهر السادس من الحمل

بدء الأمهات في الشهور الأولى من الحمل بالتساؤل عن اسباب نزول افرازات بنية بالشهر السادس. وليس هناك ما هو أكثر إثارة للقلق من الافرازات البنية التي تحدث خلال الشهور الأخيرة من الحمل، وخاصة في الشهر السادس. فما هي أسباب هذه الافرازات؟ وما هي الإجراءات التي يجب اتخاذها عند حدوثها؟ في هذا المقال، سنقدم لكل الأمهات المتوقعات معلومات مثيرة حول أسباب هذه الافرازات وكيفية التعامل معها بسهولة.
تعريف اسباب نزول افرازات بنية بالشهر السادس
تعريف الإفرازات البنية خلال الشهور السادسة من الحمل تشير إلى وجود الدم في الإفرازات المهبلية، وتعتبر ظاهرة شائعة وغالبًا لا تدعو للقلق، ولكن قد تشير أحيانًا إلى وجود مشاكل صحية تحتاج لتقييم وعلاج طبي.
أهمية استشارة الطبيبة المتابعة
من الأهمية البالغة استشارة الطبيبة المتابعة في حالة ظهور أي إفرازات بنية في الشهر السادس من الحمل، حيث يمكنها تقديم التوجيه اللازم والتأكد من سلامة الحمل وصحة الجنين.
اقرا ايضاً: تأخر الدورة الشهرية مع ألم أسفل البطن والظهر للمتزوجة
الأسباب العضوية
تغيرات وظيفية طبيعية في الرحم
تتسبب تغيرات وظيفية طبيعية في الرحم في ظهور الإفرازات البنية أثناء الحمل، حيث يتم إفراز كمية صغيرة من الدم القديم. وفي الغالب، تكون هذه الإفرازات طبيعية ولا تشكل أي خطورة على الأم والجنين.
زيادة نشاط الجنين
زيادة نشاط الجنين في الشهر السادس من الحمل أمر طبيعي ويدل على تطور الجنين. قد تشعر الأم بحركات قوية ونشاط متزايد للجنين، مما يعكس صحة جيدة وسلامة الحمل.
عدوى الجهاز التناسلي
عدوى الجهاز التناسلي هي إحدى الأسباب المحتملة لنزول افرازات بنية في الشهر السادس من الحمل. قد تحدث هذه العدوى بسبب تراكم البكتيريا أو الفيروسات في المنطقة الحساسة، وقد تسبب أعراضًا مثل الحكة والاحمرار. من الضروري استشارة الطبيبة المتابعة لتقييم الحالة وتوجيه العلاج المناسب.

الأسباب الوراثية
العوامل الوراثية المؤثرة على الحمل
العوامل الوراثية المؤثرة على الحمل هي جزء مهم من تفسير أسباب نزول افرازات بنية في الشهر السادس من الحمل. قد تؤثر على الحمل بأشكال مختلفة وقد يكون لها تأثير على صحة الجنين.
العوامل الوراثية المؤثرة على الجنين
تعد العوامل الوراثية من العوامل المؤثرة بشكل كبير على صحة الجنين. قد تؤدي هذه العوامل إلى العيوب الهيكلية في بنية الجنين وتقييد نموه. يجب أن يتم اختيار العلاج المناسب واستشارة الطبيب المختص لمراقبة ورعاية الحمل بشكل مناسب.
تعرفِ على: الحمل غير المخطط له وتأثيره على صحة الجنين
الأسباب النفسية
التوتر والقلق
التوتر والقلق يمكن أن يكونا أحد العوامل التي تسبب نزول افرازات بنية خلال الشهر السادس من الحمل. من المهم الحفاظ على راحة العقل والجسم وتجنب أي مصادر للتوتر والقلق لتجنب حدوث أي تغيرات غير طبيعية.
التغيرات الهرمونية في جسم المرأة الحامل
تتعرض النساء الحوامل لتغيرات هرمونية في جسمهن خلال فترة الحمل، وهذه التغيرات الهرمونية يمكن أن تؤدي إلى ظهور الإفرازات المهبلية. وتعتبر هذه الإفرازات طبيعية وغالبًا ما تكون بدون أي مشكلة.
كيفية التشخيص والعلاج
الفحوصات اللازمة للتشخيص
الفحوصات اللازمة للتشخيص تتطلب زيارة الطبيب المختص وعمل الاختبارات المناسبة، بما في ذلك فحص المهبل وتحليل الإفرازات البنية، لتحديد سبب نزولها في الشهر السادس من الحمل.
الخطوات الواجب اتباعها لعلاج المشكلة
لعلاج مشكلة الافرازات البنية للحامل، يجب على النساء اتباع الخطوات الصحيحة واللازمة. ينصح بزيارة الطبيب المختص لتشخيص المشكلة واختيار العلاج المناسب. كما ينبغي الحرص على تجنب المشروبات الكحولية والاهتمام بالراحة وعدم المجهد. تعتبر حسن الرعاية الصحية في الشهور الأخيرة من الحمل أمرًا هامًا. ويجب أيضًا الاهتمام بتحليل الأعراض والتواصل المستمر مع الطبيب المختص.
الاحتياطات الواجب اتباعها
تجنب المشروبات الكحولية والمنبهات
يُنصَح بتجنب تناول المشروبات الكحولية والمنبهات خلال فترة الحمل، حيث أنها قد تسبب أضرارًا على الجنين. من الأفضل اتباع نمط حياة صحي وتجنب استخدام هذه العوامل المؤثرة.
الحرص على الراحة وعدم المجهد
يجب على الحامل الحرص على الراحة وعدم المجهد خلال الشهور الأخيرة من الحمل. يمكن أن يساعد الاسترخاء وتجنب الأنشطة الشاقة في تقليل احتمالية زيادة الإفرازات البنية وحدوث أي مشاكل أخرى.
أهمية حسن الرعاية الصحية في الشهور الأخيرة من الحمل
في الشهور الأخيرة من الحمل، يصبح حسن الرعاية الصحية أكثر أهمية من أي وقت مضى. يجب على الأم الحامل أن تهتم بصحتها وصحة الجنين والاستمرار في زيارة الطبيبة المختصة بانتظام.
للمزيد: حركة الجنين في الاسبوع السابع عشر من الحمل
الاهتمام بتحليل الأعراض والتواصل مع الطبيبة المختصة.
من الضروري الاهتمام بتحليل أي أعراض غير طبيعية والتواصل مع الطبيبة المختصة في حال ظهور أفرازات بنية في الشهر السادس من الحمل. يجب البقاء هادئة والاطلاع على المعلومات الطبية الموثوقة لضمان الرعاية الصحية للأم والجنين.
قد يهمك:-
